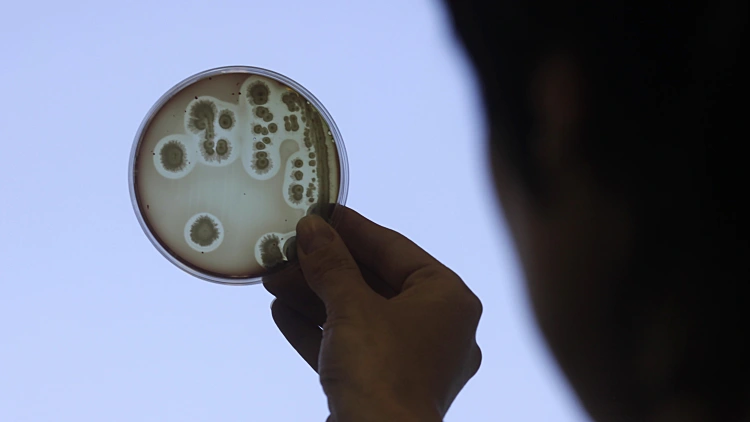
תרבית אי-קולי

הסכנה השקטה: חיידקים מזהמים נמצאים בכל מקום בו אנו נוגעים
מבדיקה שערכו חדשות 10 בשיתוף האגודה לבריאות הציבור עולה כי על כל חפץ שמקיף אותנו נמצאות אלפי מושבות חיידקים. על כפתור המעלית: 1,030 מושבות, על מקלדת המחשב יותר מ-7,000 והשיאן הוא המקרר עליו נמצאות כמעט 20 אלף מושבות. "הפתרון הוא לשטוף ידיים בסבון או באלכוהול", מסבירים המומחים
(4:19 דקות)
אדם נוגע בפנין בין 3 ל-5 פעמים בממוצע בכל דקה, ובכל פעם מעביר לגופו מהסביבה כמות אדירה של חיידקים. כדי לבדוק את גודל המסכנה, ערכנו בדיקה יחד עם האגודה לבריאות הציבור וספרנו את כמות החיידקים שנמצאים על המכשירים בהם אנחנו משתמשים מדי יום. "אנחנו רואים שבאופן מפתיע יש הרבה חיידקים גם במקומות שלא חשבנו עליהם", אמרה רונית לנג, מנהלת המעבדה של האגודה.
אולם למעשה, אין תקן שקובע מעל איזו כמות של חיידקים מדובר בסכנה לציבור. על כל חפץ שמסביבנו יש מיליוני חיידקים, ואפשר לומר שכמה מושבות אינן נוראיות, אבל כשמדובר במאות או אלפי מושבות המקום מזוהם.
על כפתורי המעלית מצאנו 1,030 מושבות, בעוד שרק לשם השוואה על אסלת שירותים נמצאו אלף בלבד. במכונת התשלום של החנייה היו 1,380 מושבות ובלחצנים של מעברי החצייה - 1,260. גם מעקה המדרגות הנעות, זה שמונע נפילה מזוהם ביותר, ועליו נמצאו יותר מ-1,100 מושבות. בכספומט תמשכו לא רק מזומנים, וספירת החיידקים שם מגיעה כמעט ל-1,500 ובידיות האוטובוס 2,650.
קבוצת הסיכון: ילדים ותינוקות
פרופסור אלי סומך, מומחה למחלות זיהומיות בבית החולים וולפסון, אמר כי כאשר מקום מאוכלס בחיידקים מרובים, בעיקר כאלו שגורמים למחלות באדם, בעור שהוא לא שלם (פצוע) זה מקום חדירה לעור ולרקמות יותר עמוקות. "אם אותם אנשים יגעו במקומות האלו אז יש חשש להדבקות", הוא ציין.
האוכלוסייה היותר חשופה לזיהומים היא כמובן התינוקות והילדים. לא סתם רופאים ממליצים לשטוף ידיים לפני טיפול בהם. "ידיים מזוהמות זה אחד האמצעים היעילים ביותר להעברת זיהומים", הוסיף פרופסור סומך.
בסביבת עבודה רגילה, שלא נמצאת ברחוב, המצב לא פחות מסוכן. על ידי כיסא נמצאו 1,260 מושבות, על הטלפון הסלולארי יותר מ-2,800. על מייבש היידים בישרותים היו יותר מ-3,800 ועל הידית מספר דומה. אבל הנתון המזעזע ביותר - על מקלדת המחשב ישנם יותר מ-7,000 מושבות כאלו. אך ללא ספק מלך הזיהומים הוא המקרר, עליו נמצאו לא פחות מ-19,800 מושבות.
"לא להכניס לפה, לא להכניס לעיניים ולא להכניס לפה", מזהירה מנהלת המעבדה. אז מה עושים? "אחרי שטיפת ידיים יש ירידה של פי 10 במספר המושבות", היא הוסיפה. פרופסור סומך מוסיף עצה משלו: "לחטא עם תמיסת אלכוהול, לחכות מספר שניות שיתייבשו וזה שווה ערך לשטיפה בסבון. זה אמצעי יעיל מאד, פשוט מאד ומהיר מאד", הוא הסביר.


